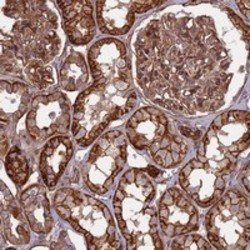

Antibody data
- Antibody Data
- Antigen structure
- References [0]
- Comments [0]
- Validations
- Immunohistochemistry [1]
Submit
Validation data
Reference
Comment
Report error
- Product number
- PAB24020 - Provider product page

- Provider
- Abnova Corporation
- Proper citation
- Abnova Corporation Cat#PAB24020, RRID:AB_11123220
- Product name
- C20orf152 polyclonal antibody
- Antibody type
- Polyclonal
- Description
- Rabbit polyclonal antibody raised against recombinant C20orf152.
- Antigen sequence
IRVCKMFRQGLRGFREYQIIETAHWKHPIFSFWDK
KMQSRVTFDTMDFIAEEGHFPPKAIQIMQKKPSWR
TEDEIQAVCNILQVLDSHRNYAEPLQLLLAKVMRF
ERFGR- Isotype
- IgG
- Storage
- Store at 4°C. For long term storage store at -20°C.Aliquot to avoid repeated freezing and thawing.
No comments: Submit comment
Supportive validation
- Submitted by
- Abnova Corporation (provider)
- Main image
- Experimental details
- Immunohistochemical staining of human kidney with C20orf152 polyclonal antibody (Cat # PAB24020) shows strong cytoplasmic and membranous positivity in cells in tubules and cells in glomeruli at 1:200-1:500 dilution.
- Validation comment
- Immunohistochemistry (Formalin/PFA-fixed paraffin-embedded sections)